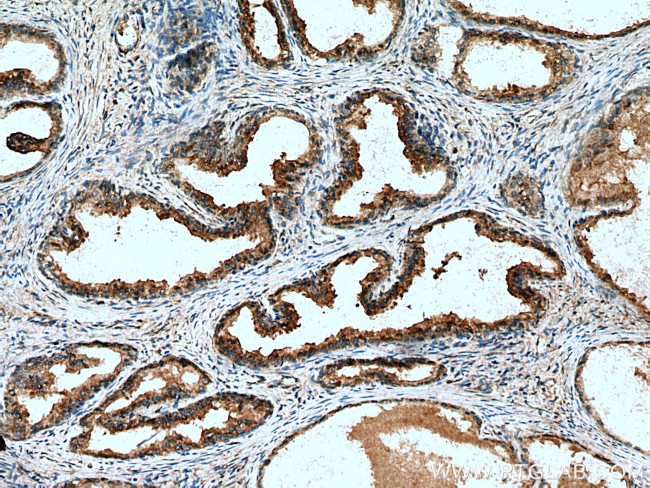
SPON2 Antibody in Immunohistochemistry (Paraffin) (IHC (P))
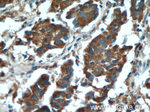
SPON2 Antibody in Immunohistochemistry (Paraffin) (IHC (P))
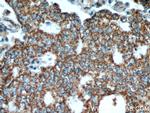
SPON2 Antibody in Immunohistochemistry (Paraffin) (IHC (P))

Search
Proteintech
SPON2 Polyclonal Antibody
{{$productOrderCtrl.translations['antibody.pdp.commerceCard.promotion.promotions']}}
{{$productOrderCtrl.translations['antibody.pdp.commerceCard.promotion.viewpromo']}}
{{$productOrderCtrl.translations['antibody.pdp.commerceCard.promotion.promocode']}}: {{promo.promoCode}} {{promo.promoTitle}} {{promo.promoDescription}}. {{$productOrderCtrl.translations['antibody.pdp.commerceCard.promotion.learnmore']}}
产品信息
20513-1-AP
种属反应
已发表种属
宿主/亚型
分类
类型
抗原
偶联物
形式
浓度
规格
纯化类型
保存液
内含物
保存条件
运输条件
产品详细信息
Immunogen sequence: ESICSARAP AKYSITFTGK WSQTAFPKQY PLFRPPAQWS SLLGAAHSSD YSMWRKNQYV SNGLRDFAER GEAWALMKEI EAAGEALQSV HEVFSAPAVP SGTGQTSAEL EVQRRHSLVS FVVRIVPSPD WFVGVDSLDL CDGDRWREQA ALDLYPYDAG TDSGFTFSSP NFATIPQDTV TEITSSSPSH P (32-221 aa encoded by BC002707)
靶标信息
Cell adhesion protein that promotes adhesion and outgrowth of hippocampal embryonic neurons. Binds directly to bacteria and their components and functions as an opsonin for macrophage phagocytosis of bacteria. Essential in the initiation of the innate immune response and represents a unique pattern-recognition molecule in the ECM for microbial pathogens. Binds bacterial lipopolysaccharide (LPS).
仅用于科研。不用于诊断过程。未经明确授权不得转售。
生物信息学
蛋白别名: Differentially expressed in cancerous and non-cancerous lung cells 1; DIL-1; DKFZp686G21139; FLJ16313; FLJ22401; FLJ34460; Mindin; spondin 2, extracellular matrix protein; Spondin-2; unnamed protein product
基因别名: DIL-1; DIL1; M-SPONDIN; MINDIN; SPON2; UNQ435/PRO866
UniProt ID: (Human) Q9BUD6
Entrez Gene ID: (Human) 10417